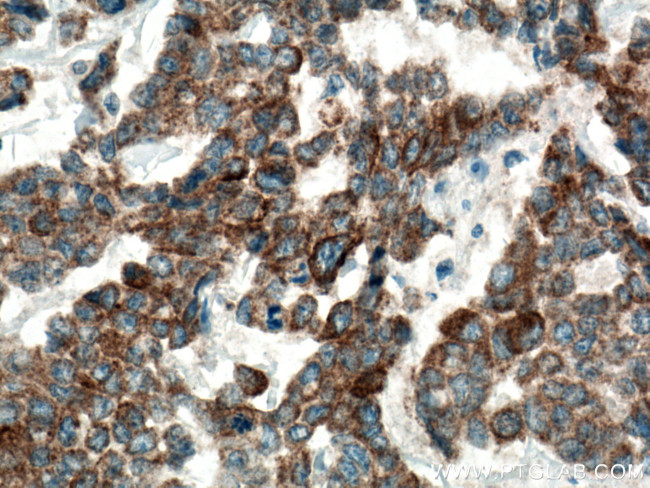
DUSP13 Antibody in Immunohistochemistry (Paraffin) (IHC (P))

Search
Proteintech
DUSP13 Polyclonal Antibody
{{$productOrderCtrl.translations['antibody.pdp.commerceCard.promotion.promotions']}}
{{$productOrderCtrl.translations['antibody.pdp.commerceCard.promotion.viewpromo']}}
{{$productOrderCtrl.translations['antibody.pdp.commerceCard.promotion.promocode']}}: {{promo.promoCode}} {{promo.promoTitle}} {{promo.promoDescription}}. {{$productOrderCtrl.translations['antibody.pdp.commerceCard.promotion.learnmore']}}
产品信息
10909-1-AP
种属反应
宿主/亚型
分类
类型
抗原
偶联物
形式
浓度
规格
纯化类型
保存液
内含物
保存条件
运输条件
产品详细信息
Immunogen sequence: MDSLQKQDL RRPKIHGAVQ ASPYQPPTLA SLQRLLWVRQ AATLNHIDEV WPSLFLGDAY AARDKSKLIQ LGITHVVNAA AGKFQVDTGA KFYRGMSLEY YGIEADDNPF FDLSVYFLPV ARYIRAALSV PQGRVLVHCA MGVSRSATLV LAFLMIYENM TLVEAIQTVQ AHRNICPNSG FLRQLQVLDN RLGRETGRF (1-198 aa encoded by BC009778 )
靶标信息
DUSP13, a novel DSP, is a member of highly conserved Protein-tyrosine phosphatase super family. Members of this family cooperate with protein kinases and play a vital role in cell cycle regulation. DUSP13 consists of a conserved catalytic domain and is expressed specifically in the testis and skeletal muscle. Based on mRNA localization and expression studies during development, DUSP13 is suggested to be expressed as 3 isoforms due to alternative splicing. Reports suggest DUSP13 might be involved in the regulation of meiosis and differentiation of testicular germ cells during spermatogenesis.
仅用于科研。不用于诊断过程。未经明确授权不得转售。
篇参考文献 (0)
生物信息学
蛋白别名: Branching-enzyme interacting DSP; Dsp13-like protein; dual specificity phosphatase 13; Dual specificity phosphatase SKRP4; dual specificity protein phosphatase 13; Dual specificity protein phosphatase 13A; Dual specificity protein phosphatase 13B; dual specificity protein phosphatase isoform MDSP; Dual specificity tyrosine phosphatase TS-DSP6; dual-specificity tyrosine phosphatase TS-DSP6; DUSP13; DUSP13A; DUSP13B; FLJ32450; MDSP; Muscle-restricted DSP; muscle-restricted dual specificity phosphatase; muscle-restricted dual specificity phosphatase; testis and skeletal muscle-specific dual specificity phosphatase; RP11-487I5.6; testis and skeletal muscle-specific dual specificity phosphatase; Testis- and skeletal muscle-specific DSP; Testis- and skeletal muscle-specific DUSP; Testis- and skeletal-muscle-specific DSP; unnamed protein product
基因别名: BEDP; DUSP13; DUSP13A; DUSP13B; Gm1203; LMW-DSP6; MDSP; SKRP4; TMDP; TS-DSP6
UniProt ID: (Human) Q6B8I1, (Mouse) Q9QYJ7
Entrez Gene ID: (Human) 51207, (Mouse) 27389, (Rat) 361002